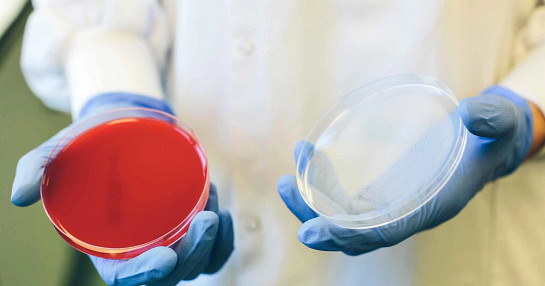
open-petri-dish

Oncology
Insights on the major trends in oncology including the development of targeted therapies in clinical trial designs and patient care.

De-risking clinical development of precision medicines in oncology
This whitepaper reviews the most pressing challenges and opportunities facing the oncology therapeutic landscape in the emerging era of precision medicine, and reports on how those opportunities and challenges vary by organisational size and region.

ICON survey report: Innovation in oncology - Accelerating R&D in an evolving landscape
In Spring of 2024, ICON conducted a survey of 104 professionals engaged in oncology drug development in North America and Europe, representing organisations ranging from small to large biotech and pharmaceutical companies.

Advances in imaging biomarkers: Estimating drug efficacy with tumour growth rate modelling
This whitepaper compares the use of imaging biomarker methodologies such as RECIST 1.1 with novel tumour growth rate (TGR) modelling. Using this methodology eliminates the need for a comparable control arm which can reduce research costs. TGR modelling also more efficiently captures heterogeneous tumour measurements and whole-body tumour burden.

Strategies for commercialising oncology treatments for young adults
In this whitepaper we delve into the dynamic landscape of oncology treatments tailored specifically for young adults. As cancer incidence among young individuals surges globally, it's imperative to explore innovative strategies that address their unique needs and challenges.

Approaching the CAR T-cell therapy horizon
Approved CAR T-cell therapies have shown remarkable results in patients with certain types of blood cancers, but further innovations are needed before the technology can reach its full potential. In this whitepaper, we explore the most exciting clinical developments in CAR T-cell therapy, and relate them to limitations of approved therapies.

Research strategies to support the acceleration of oncology antibody drugs to market
This presentation will address important issues in antibody drug development, including choosing the right biomarker, drug formulation and manufacturing. It will also discuss critical aspects of clinical trial design and leveraging regulatory pathways, in addition to outlining the differences between fast track, break through therapy, priority review regulatory designations and accelerated approval pathways.

From genomics to the coming of age glycomics
Discover how glycan biomarkers are quickly becoming key elements of cancer, cardiovascular, and gastrointestinal research, setting the stage for a new golden age of epigenetic research and personalised therapeutics.
Multi-diagnostic approaches for patient selection biomarkers in immuno-oncology
The development of diagnostic tests which can predict patient response to these therapies are crucial to the clinical success of an immunotherapy candidate. This webinar recording helps to:
- Define the different classes of immunotherapy being developed for cancer treatment
- Identify the utility and limitations of current biomarkers for the selection of patients for checkpoint inhibitor therapy
- Compare/contrast methods and assays being used for biomarker analysis
Evolving oncologic development in the decades ahead
Successive revolutions of prevention strategies and precision medicine in the past two decades have contributed to lowering the mortality rate for the ten most prevalent cancers by more than 10% across most of Europe, Asia, and North America. In the coming years, emergent therapeutic strategies, including immuno-oncologics and liquid biopsy-based companion diagnostics, may yield some of the most transformative clinical benefits to date. Yet, oncology pipelines remain rife with challenges. This whitepaper provides specific ideas and innovative approaches that make a real difference to the successful conduct of industry-sponsored clinical trials.
Optimising oncology clinical research through site partnership and investigator support
The goal of oncology drug development is to bring effective treatments and improved individual care to patients suffering from cancer. The process to get a new therapy approved by the FDA may take 10–15 years and requires the timely completion of numerous clinical trials. The success of the process rests on finding and supporting the investigators and site staff that ultimately recruit the patients for the studies. CROs can reduce barriers to clinical research participation for sites, by finding ways to create administrative efficiencies, keep investigators engaged throughout the process,
Immuno-oncology setting the scene
Immuno-oncology (I-O) plays an increasingly important part in cancer treatment, utilising the body’s own immune system to fight the disease. Although not a new concept, I-O has progressed considerably in the last 10-15 years with approvals for numerous I-O therapies including vaccines, cytokines, tumour-directed monoclonal antibodies, and immune checkpoint inhibitors.
Oncology clinical development media contributions

Marking the Path Ahead: Integrating Oncology Biomarkers Into Clinical Development' has published
In this article, ICON experts discuss strategies to implement biomarkers in clinical development, saving sponsors time and money while positioning therapies for success.

Combination therapies may be the future of oncology – How can we navigate development challenges today?
In this article, ICON experts discuss common ways oncology therapies are combined to achieve synergistic effects, and considerations oncology developers should employ to de-risk combination therapy development.

Advances in imaging biomarkers: Estimating efficacy with tumour growth rate modelling
Imaging biomarkers are an essential part of oncology trials, tracking the efficacy of the new treatment and comparing it to the existing gold standard therapies. The insights gleaned from imaging biomarkers steer the course of oncology clinical trials, informing decision-making and endpoints. This article discusses the benefits of tumour growth rate modelling.

Oncology R&D: emerging therapies and new challenges
Worldwide demand for cancer therapies is set to soar – and biomanufacturers are in the spotlight. Explore emerging industry data to distinguish trends and prepare for the future of oncology.

To be precise: How oncology therapies can stand out in a diverse, uncertain landscape
Targeted product profiles and biomarkers for patient screening are essential elements of success for oncology treatment developers, according to our recent survey. This article explores why both prove challenging for drug developers.

Strategies for commercialising oncology treatments for young adults
This article explores the imperatives and strategies for commercialising oncology treatments targeting young adults, highlighting the need for innovative regulatory and commercial strategies to ensure successful market entry and improved patient outcomes.

Survey shows varied views on impact of new cancer drugs
This article published in The Pharma Letter highlights findings from an ICON survey has found that despite the increasing investment in emerging oncology-related therapeutics, developers have varied views on the impact of new cancer drugs for patients.

Innovation and flexibility in long-term follow-up studies
Read insights from Harpreet Gill VP, Real World Solutions, on how sponsors can optimise their LTFU studies to be flexible and cost-effective, with strategic planning and innovation, overcoming challenges while capturing valuable data insights.
Oncology blogs
-

Blog: Navigating complexity in oncology cell and gene therapy clinical trials
Cell and gene therapies (CGT) are playing an increasingly important role in treating oncology patients.
-

Blog: Innovation in oncology drug development: A focus on patient benefits
Improved diagnostic technologies, prevention methods and the advent of targeted therapeutic approaches have together contributed to lowering the mortality rate for the 10 most prevalent cancers
-

Blog: Multidiagnostic approaches for patient selection biomarkers in immuno-oncology
Advances in our understanding of cancer biology and the tumour microenvironment (TME), have led to the development of personalised drug and therapy designs to better prevent disease progression and relapse
-

Blog: Immunotherapy in cancer treatment
Immunotherapy has been the focus of medical research for many years, and scientists continue to experiment with and learn about the form of therapy in cancer treatment.
-

Blog: Innovation in Oncology drug development
Significant progress has been made in our understanding of the molecular lesions responsible for tumor cells to exhibit uncontrolled growth.
-

Blog: Oncology Clinical Trials in Asia Pacific
Although Asia Pacific (APAC) is sometimes referred to as a homogenous unit, it is a heterogeneous region, with divergent countries, languages, populations and cultures.
-

Blog: Patient Centricity in Oncology Trials
Patient centric strategies to focus more on patient needs and increase efficiencies.
-
Blog: Smart Bioanalytical Strategies in Immuno-Oncology Trials
Biomarker-based methods and how they can be leveraged to add value to oncology trials.
Receive more insights on oncology from ICON
Please visit ICON's Preference Centre and select 'oncology' under 'Therapeutic Areas of Interest' to receive new insights on oncology.
ICON's Oncology capabilities
Oncology services
ICON’s Oncology Solution expedites every aspect of a cancer drug trial. It combines global experience in all Phases of oncology drug development (including early phase, immuno-oncology and cell and gene therapies) with expertise in tumor imaging, laboratory (including PK/PD and Biomarkers) IVRS, central data management, electronic data capture and regulatory oncology issues.



